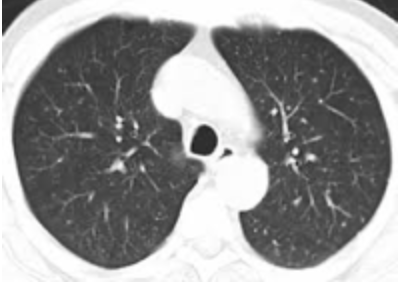

(Kliknij w ilustrację, aby ją powiększyć)
Wprowadzenie
COVID-19 pojawił się w Europie i obu Amerykach w 2020 r., po pojawieniu się nowego wirusa z Chin w 2019 r. Ten nowy wirus należy do dobrze znanej rodziny koronawirusów, która wywołała już dwie szczególnie poważne epidemie w 2003 i 2012 r. Nowy wirus nazywa się SARS-CoV-2, trzeci koronawirus odpowiedzialny za zespół ciężkiej niewydolności oddechowej (ARDS). Ciężkość tego zespołu charakteryzuje się głównie hipoksemią, czyli niedoborem tlenu we krwi. Ta ciężka niewydolność płuc występuje u stosunkowo niewielkiej liczby pacjentów zakażonych SARS-CoV-2, z których większość nie ma objawów albo ma tylko chorobę grypopodobną lub nawet przeziębienie. Pierwsze statystyki dotyczące profilu przypadków COVID-19 są dostępne dla Szwajcarii.
W przypadku pacjentów najbardziej dotkniętych chorobą, głównie osób starszych i / lub osób osłabionych przez jedną lub więcej chorób przewlekłych (niewydolność serca, układu oddechowego i nerek, cukrzyca, wysokie ciśnienie krwi, otyłość itp.), śmiertelność byłaby nieco wyższa niż w przypadku grypy sezonowej dokładne dane nadal wymagają oceny.
Liczby te są dziś nadal kontrowersyjne, a niektórzy naukowcy i lekarze argumentują, popierając to dowodami, że śmiertelność została przeszacowana przez oficjalne ośrodki zdrowia:
https://www.mondialisation.ca/coronavirus-et-nombres-de-deces-douteux/5645433
https://powerandharmony.com/covid19-terrorisme-mediatique-manipulation-chiffres/
https://powerandharmony.com/covid19-les-chiffres-ne-mentent-pas/
Wydało się ważne, aby wyjaśnić kilka punktów związanych z COVID-19, jego diagnostyką kliniczną i radiologiczną oraz głównymi punktami postępowania na oddziale intensywnej terapii. Skończę na luce między prezentacją choroby w ostrej fazie (marzec-kwiecień 2020) a jej prezentacją dzisiaj.
COVID-19 w intensywnej terapii: Ciężkie przypadki ARDS
Jedną z najpoważniejszych patologii, najczęściej spotykanych w intensywnej terapii, jest ARDS (zespołu ostrej niewydolności oddechowej), który wpływa na czynność układu oddechowego, a mianowicie na dotlenienie krwi (O2) i eliminację dwutlenku węgla (CO2), produktu przemiany materii, poprzez uszkodzenie narządów oddechowych, płuc.
ARDS to inaczej zespół ostrej niewydolności oddechowej.
Opisany w 1967 r., ARDS nadal stanowi 10% przyjęć na oddział intensywnej terapii, a śmiertelność wynosi 40–50%. (Ashbaugh DG, Bigelow DB, Petty TL, Levine BE, „Ostra niewydolność oddechowa u dorosłych”, The Lancet 1967; 2: 319-32 https://www.ncbi.nlm.nih.gov/pmc/articles/PMC5537110/) . ARDS powoduje głównie upośledzenie utleniania krwi.
Natlenienie – O2
Zwykle podczas wdechu pobieramy tlen (O2) z otaczającego powietrza, a podczas wydechu usuwamy dwutlenek węgla (CO2). Ta aktywność jest fundamentalna. Oddychamy około 20000 razy dziennie, 550 milionów razy w ciągu 75 lat życia. Otaczające powietrze, na normalnej wysokości odpowiadającej poziomowi morza, zawiera 21% tlenu, a to więcej niż wystarczające. Dane mierzone we krwi (w miarę możliwości tętniczej) to PaO2 (ciśnienie parcjalne tlenu we krwi tętniczej) i SaO2 (nasycenie hemoglobiny w krwi tętniczej tlenem). Pomiaru SaO2 dokonujemy przy pomocy czujnika zwanego pulsoksymetrem. Poziom nasycenia krwi tlenem, zmierzony pulsoxymetrem okreśalmy jako SpO2.
Na oddziale intensywnej terapii monitorujemy SpO2 za pomocą czujnika na czubku palca, czasem przy uchu.
W ciężkich przypadkach łączymy to z regularnym monitorowaniem gazometrii tętniczej (pobieranie krwi przez cewnik umieszczony w tętnicy), która podaje między innymi PaO2, SaO2 oraz poziom hemoglobiny – białka przenoszącego tlen we krwi.
Ważnymi mierzonymi parametrami są:
- Poziom hemoglobiny (nośnik tlenu we krwi) …
- Ilość tlenu transportowanego przez hemoglobinę (SaO2), mierzona w sposób ciągły przy pomocy czujnika (SpO2) .
- PaO2 lub ciśnienie parcjalne tlenu we krwi tętniczej (w mmHg)
Ten wykres ilustruje zależność między Sa02 (wysycenie tlenem hemoglobiny we krwi tętniczej w %) a PaO2 (w mmHg).
Jak widać, zależność ta nie jest liniowa, ale reprezentowana przez sigmoidalną krzywą. Oznacza to, że spadek SaO2 (odzwierciedlony przez SpO2) o 10% (100 do 90%) oznacza spadek PaO2 o 40 mmHg (100 do 60 mmHg)!
Tlen jest niezbędny. Niektóre narządy są od niego całkowicie zależne, a pozbawienie tlenu na kilka minut może mieć poważne konsekwencje, szczególnie dla mózgu lub serca. Spadek tlenu we krwi nazywany jest hipoksemią i na tym polega problem z ARDS.
To pierwszy istotny problem związany z COVID-19: ciężka hipoksemia.
Wstępna prezentacja COVID-19 jest mylona z prezentacją ARDS, stanowiącą średnio (warianty krajowe) 10% przyjęć na oddział intensywnej terapii i zabijającą około jednego na dwóch chorych. Pogorszenie rokowania (szans przeżycia) przez występowanie schorzeń współistniejących (otyłość, przewlekła patologia, wiek >60 lat) było już dobrze znane we wszystkich przypadkach ARDS, od czasu ich opisania w 1967 roku.
Leczenie ARDS
Oprócz leczenia przyczynowego, leczenie objawowe hipoksemii było już dawno dobrze skodyfikowane i niewiele się zmieniło od 30 lat. Należy zwiększyć stężenie tlenu w powietrzu wdychanym przez pacjenta za pomocą metody nieinwazyjnej (wentylacja (przez maskę lub kaniulę nosową) lub, w cięższych przypadkach, wentylacja inwazyjna z intubacją tchawicy i podłączeniem pacjenta do maszyny (respiratora). Ciśnienie (dodatnie) jest w ten sposób przeniesione do pęcherzyków płucnych, w których zachodzi wymiana gazowa (O2 i CO2). W ten sposób pęcherzyki pozostają otwarte, a wymiana gazów może odbywać się w sposób ciągły.
Lekarz może zwiększyć stężenie tlenu we wdychanym powietrzu nawet do 100% (czysty tlen), czyli 5x więcej niż w otaczającym powietrzu (21% na poziomie morza).
Oddychanie czystym tlenem nie jest idealne, ale pilną potrzebą jest podniesienie PaO2 dla podtrzymania pracy najważniejszych narządów i uniknięcia śmierci.
Innym podejściem terapeutycznym stosowanym w ARDS jest umieszczenie intubowanego i śpiącego pacjenta na brzuchu. To podejście, stosowane dziś w leczeniu COVID-19, jest znane od dawna i może być korzystne w każdym przypadku ARDS, niezależnie od przyczyny.
Ta praktyka nazywa się pozycją podatną / pozycjonowaniem podatnym.
Niektóre osoby będą lepiej reagować (pod względem korzyści z natlenienia) niż inne. Aby się tego dowiedzieć, musisz spróbować co najmniej dwóch sesji od 8 do 18 godzin.
W ARDS, patologii leżącej u podstaw COVID-19, narządem dotkniętym chorobą są płuca, co skutkuje obrazowaniem:
Pęcherzyki płucne są wypełnione powietrzem, (Kolor czarny na obrazie tomografii komputerowej.
Abnormalny skan tomografii komputerowej.
OSTRZEŻENIE, te ilustracje nie są specyficzne dla COVID-19! Widzimy je w przypadkach pneumopatii naciekowej, w tym ostrej hipoksemicznej śródmiąższowej pneumopatii, która może być obecna przy krwotokach wewnątrz pęcherzyków płucnych, pneumopatiach polekowych (amiodaron), toksycznych pneumopatiach i chorobach układu, a także przy zapaleniu naczyń. Należą one do grupy patologii płuc zgrupowanych pod ogólnym terminem ARDS.
ARDS może być spowodowany wieloma przyczynami, wewnątrz- lub pozapłucnymi, zakaźnymi lub niezakaźnymi.
Przyczyny śródpłucne:
- Bakteryjne, wirusowe zapalenie płuc (grypa, syncitial Virus lub RSV, SARS)
- Chemiczna pneumopatia (wdychanie płynu trawiennego) lub wdychanie dymu
- Uraz klatki piersiowej
Przyczyny pozapłucne:
- Zapalenie trzustki (uogólnione zapalenie trzustki z martwicą)
- Zakażenia pozapłucne z ciężką posocznicą (zakażeniem) i / lub wstrząsem septycznym
- Rozległe oparzenia
- Wstrząs kardiogenny (niewydolność serca dowolnego pochodzenia)
- Itp.
Zmiany wyglądające jak zamarznięta, matowa szyba są typowe dla ARDS, a nie dla jakiejś szczególnej przyczyny.
Występują one w szczególności w zakaźnym zapaleniu płuc z tak zwanymi atypowymi zarazkami, takimi jak Mycoplasma Pneumoniae, Chlamydia Pneumoniae czy Legionella Pneumophila, ale także w niezakaźnych pneumopatiach.
Zawsze należy stosować diagnozę różnicową, zwłaszcza u osób z jednym lub kilkoma ciężkimi chorobami współistniejącymi (cukrzyca, otyłość, przewlekła choroba nerek, płuc lub serca itp.), co ma miejsce w przypadku większości osób przyjmowanych na oddziały intensywnej terapii w okresie COVID.
Problemem jest podtrzymanie diagnozy COVID bez rozważenia innych możliwych przyczyn, zwłaszcza w przypadku negatywnego wyniku RT-PCR.
Objawowe leczenie ciężkiego zapalenia płuc wywołanego przez COVID-19 jest leczeniem ARDS:
- Nieinwazyjna tlenoterapia (maska, kaniula nosowa)
- Tlenoterapia inwazyjna (intubacja dotchawicza)
- Dodatnie ciśnienie w pęcherzykach płucnych
- Naprzemiennie ułożenie na brzuchu i na plecach
Do zapamiętania:
Ciężkie zapalenie płuc wywołane przez COVID-19 przejawia się jako ARDS z ciężką hipoksemią. Innym dobrze znanym wirusowym zapaleniem płuc, które może wywołać ARDS, jest grypa. ARDS scharakteryzowano w 1967 r. W ciągu 50 lat śmiertelność utrzymuje się na wysokim poziomie 40–50%, czyli 1 pacjent na 2 chorych. Postępowanie jest ustandaryzowane, zasadniczo objawowe i ukierunkowane na hipoksemię (brak tlenu we krwi).
COVID-19 w intensywnej terapii: nie tylko ARDS
Dość szybko odkryliśmy, że zespołowi ARDS związanemu z zapaleniem płuc COVID-19 towarzyszyło szczególne powikłanie: skłonność do zakrzepicy. Naczynia krwionośne, które dostarczają krew, a tym samym tlen do narządów organizmu, umożliwiają swobodny przepływ krwi. Czasami jednak tworzy się skrzeplina (niedrożność) i utrudnia przepływ krwi.
Taka niedrożność może wystąpić w żyle lub tętnicy.
Jej istotne konsekwencje to:
- Zatorowość płucna w wyniku zakrzepicy żylnej, nasilająca hipoksemię pacjenta …
- Niedotlenienie ważnego narządu (serce, mózg, nerki, wątroba …) w wyniku zakrzepicy tętniczej prowadzące do niewydolności i / lub uszkodzenia narządu.
Na oddziale intensywnej terapii skłonność do zakrzepicy w kontekście ARDS, niezależnie od jej pochodzenia, była już znana i wyjaśniona długotrwałym unieruchomieniem, brakiem aktywnego (dobrowolnego) ruchu mięśni, aktywacją stanu zapalnego i koagulacją wywołaną przez zespół złożonych i współzależnych mechanizmów.
Każdy, kto był wentylowany, jak w ARDS, był już antykoagulowany (rozrzedzenie krwi) jako środek zapobiegawczy, bez czekania na wystąpienie zakrzepicy. Okazało się to jednak niewystarczające w przypadku zespołu ARDS wywołanego zapaleniem płuc COVID-19. Dlatego podawaliśmy wyższą dawkę (leczniczą, nie tylko profilaktyczną) antykoagulanta (pochodnej heparyny). Te problemy zostały przekazane przez zespół medyczny IHU-Méditerranée-Infection w Marsylii, co możemy usłyszeć tutaj, na tym filmie, w czasie 0:6:50, z ust profesora hematologii i specjalisty od koagulacji Laurence’a Camoina.
Wykrywanie w ostrej fazie zapalenia płuc COVID-19 podwyższonych stężeń antykoagulantów toczniowych i przeciwciał antyfosfolipidowych we krwi, występujących w chorobach o charakterze autoimmunologicznym, tj. chorobach, w których układ odpornościowy zwraca się przeciwko własnemu organizmowi, np. toczeń rumieniowaty układowy lub zespół antyfosfolipidowy.
Według Laurence’a Camoina stwierdzono to u 60% pacjentów hospitalizowanych i 25% pacjentów ambulatoryjnych (nie hospitalizowanych), z silnym wzrostem ryzyka zakrzepicy (zakrzepica z zatorowością płucną i / lub tętniczą). Zakrzepica tętnic mózgu powoduje udar niedokrwienny, powikłanie, które występuje również u pacjentów z ARDS po COVID, z nienormalnie wysoką częstotliwością. Jest możliwe, że jeden z pozytywnych skutków hydroksychlorochiny (Plaquenil °), występujący zwłaszcza u pacjentów leczonych w IHU-Méditerranée de Marseille, jest związany z jej korzystnym działaniem na te autoprzeciwciała.
COVID-19 w belgijskiej intensywnej terapii: moje osobiste doświadczenia od marca do maja 2020 r.
Podobnie jak wszystkie szpitale w krajach, które wybrały całkowitą i ścisłą izolację na mocy dyrektyw Światowej Organizacji Zdrowia (WHO), w marcu 2020 r. wstrzymaliśmy wszystkie nasze działania medyczne i chirurgiczne w celu przyjmowania i leczenia pacjentów z COVID-19.
Leczyliśmy łącznie 40 pacjentów w średnim wieku 61,5 lat. Najmłodszy pacjent, 30 lat. Najstarszy pacjent, 83 lata. 13 kobiet na 27 mężczyzn, co odzwierciedla światowe dystrybucję COVID-19 według płci, z przewagą mężczyzn (patrz Ilustracja 1). Średnia długość pobytu w intensywnej terapii wynosiła 20,8 dni. Śmiertelność = 40% (czyli dobrze znana śmiertelność ARDS – https://www.ncbi.nlm.nih.gov/pmc/articles/PMC5537110/). Zaintubowano 37 pacjentów i stwierdziliśmy, że czas trwania sztucznej wentylacji (z użyciem respiratora) był znacznie dłuższy niż w zwykłym ARDS (ARDS): średnio 17 dni. Z leżenia na brzuchu skorzystało 23 spośród 37 zaintubowanych (62%). Najczęściej stwierdzanymi czynnikami ryzyka były: otyłość (BMI> 30), cukrzyca, nadciśnienie.
BMI = wskaźnik masy ciała = masa podzielona przez wzrost2 , przykład: waga 100 kg wzrost 1,70 m => BMI = 100 / 1,72 = 34 = ciężka otyłość.
Zastosowane zabiegi były klasyczne, głównie te stosowane we wszystkich ARDS.
- Tlenoterapia poprzez wzbogacanie wdychanego powietrza tlenem do 100% (czysty tlen)
- Wentylacja nadciśnieniowa
- Stosowanie okresowej pozycji na brzuchu
- Antybioterapia według wskazań, jak najwcześniej
- Antykoagulacja w dawkach terapeutycznych (leczniczych)
- Kortykosteroidy: odkrywanie na nowo
W przeciwieństwie do hydroksychlorochiny, kortykosteroidy są popularne bez medialnego, politycznego lub medycznego kontrataku w leczeniu ciężkiego zapalenia płuc wywołanego przez COVID-19.
Udowodniony wpływ kortykosteroidów na ciężkie postacie Covid-19 jest „dramatycznym punktem zwrotnym”, to leczenie „ratuje życie” … Tak, z wyjątkiem tego, że korzyści wynikające z wczesnej terapii kortykosteroidami w ARDS rozlanej naciekowej chorobie płuc (rozlanej śródmiąższowa chorobie płuc) były już dawno znane. To nie jest nowe. Pneumopatia COVID-19 zachowuje się jak rozlana pneumopatia naciekowa i ma aspekt radiologiczny:
- Terapia kortykosteroidami jest leczeniem pierwszego rzutu w rozlanej naciekowej chorobie płuc. Skuteczność zależy od tego, jak wcześnie zostanie wprowadzona. Podawanie dużych dawek kortykosteroidów jest zalecane zwłaszcza w przypadku ostrej śródmiąższowej choroby płuc i krwotoków wewnątrz pęcherzyków płucnych.
Ten fragment pochodzi ze strony 11 tego pliku PDF z 2014 r. „Hipoksemiczne pneumopatie na oddziałach ratunkowych: diagnostyka i postępowanie”, SFAR (Société Française d’Anesthésie-Réanimation), autorstwa dr M. Sebbane z Montpellier.
Dziś są skutecznie stosowane na oddziałach intensywnej terapii w leczeniu COVID-19 .
COVID-19 w intensywnej terapii: kontrowersyjne metody leczenia
1- Hydroksychlorochina (HCQ lub Plaquenil °)
Wykorzystaliśmy ją na początku (marzec 2020 r.) w hospitalizacji i intensywnej terapii, aby w obliczu polemiki i zakazu ze strony wysokich władz zdrowotnych bardzo szybko ją porzucić. Jak zostało dobrze wykazane, hydroksychlorochinę należy wprowadzić wcześnie, od pierwszego dnia objawów, kiedy obciążenie wirusowe jest ważne i kiedy wirus nie wniknął jeszcze do płuc!
Dlatego należy ją stosować ambulatoryjnie, pod nadzorem lekarza pierwszego kontaktu lub lekarza pierwszego kontaktu w nagłych przypadkach. Podawanie go na oddziale intensywnej terapii, a nawet w szpitalu, późno, powyżej 2 dni od wystąpienia objawów i / lub w ciężkich postaciach, nie jest zalecane, a wręcz przeciwnie (ryzyko niepożądanych skutków ubocznych, zwłaszcza kardiologicznych).
Hydroksychlorochina jest stosowana od ponad 70 lat w różnych patologiach (choroby autoimmunologiczne, toczeń rumieniowaty, reumatoidalne zapalenie stawów, malaria …), z bardzo korzystnym profilem bezpieczeństwa.

(Kliknij w tabelę, aby ją powiększyć)
W latach 1960–2020 wyszukiwanie w PubMed (witryna archiwum medycznego), w którym szukano „przedawkowanie hydroksychlorochiny”, wykazało „tylko” 18 przypadków przedawkowania wraz z odpowiednimi artykułami. Dawki znacznie przewyższały zalecane, tym bardziej zalecane w leczeniu zakażenia COVID-19, czyli 400 mg / dobę przez 5 dni. Pomimo tych bardzo nadmiernych dawek, w tych 18 przypadkach odnotowano tylko 1 zgon i obejmował on masywne przedawkowanie (12 g) u 2,5-letniego dziecka.
Nieszkodliwość (brak zagrożenia) hydroksychlorochiny została szeroko udowodniona, szczególnie w tym retrospektywnym badaniu jednej z patologii leczonych najdłużej przez hydroksychlorochinę: reumatoidalnego zapalenia stawów.
Dr Harvey Risch, profesor epidemiologii na renomowanym Uniwersytecie Yale (Yale School of Public Health), w swoim aartykule przedstawił wyniki 7 badań ilustrujących bezpieczeństwo stosowania hydroksychlorochiny, zwłaszcza przez krótki okres czasu i przy zalecanych dawkach:
– „Te siedem badań obejmuje: 405 pacjentów z grupy wysokiego ryzyka leczonych przez dr Vladimira Zelenko, z zerową liczbą zgonów (i bez zaburzeń rytmu serca); cztery badania obejmujące łącznie prawie 500 pacjentów z grupy wysokiego ryzyka leczonych w domach opieki dla osób starszych i klinikach w całych Stanach Zjednoczonych – bez zgonów; badanie kontrolne z udziałem ponad 700 pacjentów wysokiego ryzyka w Brazylii, ze znacznie zmniejszonym ryzykiem hospitalizacji i dwoma zgonami spośród 334 pacjentów leczonych hydroksychlorochiną (a wśród 412 pacjentów leczonych HCQ, bez arytmii serca); i inne badanie z 398 dopasowanymi pacjentami we Francji, również ze znacznie zmniejszonym ryzykiem hospitalizacji (wśród 1061 pacjentów leczonych w Marsylii brak arytmii serca). – Więcej informacji można znaleźć w http: / /www.francesoir.fr/opinions-tribunes/la-cle-pour-vaincre-la-covid-19-existe-deja-nous-devons-commencer-lutiliser
Jednak hydroksychlorochina została zakazana w kilku krajach w leczeniu zakażenia COVID-19. Dlaczego zostało to zakazane?
Obrona hydroksychlorochiny w leczeniu COVID-19, związana z brakiem toksyczności, nie jest wyłączną domeną zespołu profesora Didiera Raoulta z IHU-Méditerranée-Infection w Marsylii. Na tym wykresie widzimy na zielono wszystkie kraje, które zezwoliły swoim lekarzom na wczesne przepisywanie hydroksychlorochiny pacjentom z COVID-19:
(Kliknij w wykres, aby go powiększyć)
Badania przemawiające za stosowaniem hydroksychlorochiny na bardzo wczesnym etapie zakażenia COVID-19 są liczne i poważne i dalekie od ograniczania się do krytykowanych (i wątpliwych) badań zespołu profesora Didiera Raoulta: https://hcqtrial.com . 79 badań, w tym 46 wzajemnych ocen.
Poniżej znajduje się przegląd piśmiennictwa dotyczącego stosowania hydroksychlorochiny na różnych etapach zakażenia COVID-19, stosowanej samodzielnie lub w połączeniu z azytromycyną (makrolidem antybiotyku AZT). Połączenie HCQ + AZT jest rekomendowane przez zespół profesora Didiera Raoulta i innych. Amerykański lekarz Vladimir Zelenko do tej kombinacji dodaje cynk:
- Protokół dr V. Zelenko (Stany Zjednoczone, Nowy Jork): https://internetprotocol.co/covid-19/2020/07/21/yale-harvard-professors-support-zelenkos-protocol/
Przez pięć dni. Badania te potwierdzają wartość hydroksychlorochiny we wczesnym leczeniu (jak najwcześniej od wystąpienia objawów) zakażenia COVID-19 oraz wykazują synergistyczny efekt skojarzenia z azytromycyną i cynkiem. Stwierdzono to w tych trzech badaniach opublikowanych w głównych czasopismach: https://www.ejinme.com/article/S0953-6205(20)30335-6/
Spośród 3451 pacjentów z COVID-19, 76,3% otrzymało HCQ. Współczynnik zgonów (na 1000 osobodni) dla pacjentów otrzymujących lub nie otrzymujących HCQ wynosił odpowiednio 8,9 i 15,7. Po uwzględnieniu ocen skłonności stwierdziliśmy o 30% mniejsze ryzyko zgonu u pacjentów otrzymujących HCQ.
I tutaj: https://www.ijidonline.carticle/S1201-9712(20)30534-8/fulltextom/
– Zgodnie z algorytmem leczenia opartym na protokole, u hospitalizowanych pacjentów stosowanie samej hydroksychlorochiny w skojarzeniu z azytromycyną wiązało się ze znacznym zmniejszeniem śmiertelności szpitalnej w porównaniu z nieotrzymaniem hydroksychlorochiny.
I znowu tutaj: https://www.journalajmah.com/index.php/AJMAH/article/view/30224/56706
Stosowanie hydroksychlorochiny w infekcjach wirusowych wywołanych przez SARS opisano in vitro od 2005 roku: https://www.ncbi.nlm.nih.gov/pmc/articles/PMC1232869/
Zatem hydroksychlorochina w leczeniu zakażenia COVID-19 daleka jest od bycia jedynie interwencjami czy badaniami zespołu profesora Didier Raoult w IHU-Méditerranée w Marsylii. W rzeczywistości, w niedawnym American Journal of Medicine (AJM) z 6 sierpnia 2020 r., https://www.amjmed.com/article/S0002-9343(20)30673-2/fulltext (plik PDF do pobrania) przedstawiono schemat terapeutyczny ponownie, z hydroksychlorochiną w dobrym i właściwym miejscu, połączoną z azytromycyną:
2- Cynk
Liczne badania, in vitro i in vivo, wskazują na wartość cynku jako środka przeciwwirusowego w najszerszym znaczeniu, a w szczególności w leczeniu SARS-CoV-2.
- https://www.ncbi.nlm.nih.gov/pubmed/21079686:
– Zn (2+) hamuje aktywność polimerazy RNA koronawirusa i arteriwirusa in vitro, a jonofory cynkowe blokują replikację tych wirusów w hodowli komórkowej ”. (Badanie holenderskie)
Zwróć uwagę, że utrata węchu i anomalii smaku wymieniana jako charakterystyka zakażenia COVID-19 może wynikać z niedoboru cynku, pierwiastka śladowego, który odgrywa ważną rolę w naszych mechanizmach obronnych!
Oznaki wskazujące na niedobór cynku:
- Agueusia lub zaburzenia smaku. Cynk bierze udział w syntezie gustinu, białka niezbędnego do postrzegania smaku w kubkach smakowych.
- Utrata węchu.
Te objawy, według niektórych badań, byłyby pierwszymi oznakami zakażenia koronawirusem. Dlatego jest bardzo prawdopodobne, że nadmierna stymulacja immunologiczna prowadzi do niedoboru cynku, powodując te objawy u niektórych osób. https://www.ncbi.nlm.nih.gov/pubmed/25715353 & Hiroyuki YANAGISAWA, Zinc Deficiency and Clinical Practice JMAJ 47 (8): 359-364, 2004
3- Witamina D3
Na Zachodzie często mamy braki, wymienione tutaj: https://www.ncbi.nlm.nih.gov/pmc/articles/PMC3024173/
- Nawet w najbardziej nasłonecznionych miejscach, takich jak Arabia Saudyjska i Australia, 30-50 procent dorosłych i dzieci ma niedobór witaminy D lub jest ona niewystarczająca.
Badania wykazały, że suplementacja witaminy D3 może zapobiegać ostrym infekcjom dróg oddechowych.
- Tak jak to w British Medical Journal (BMJ) w 2017 roku: https://www.bmj.com/content/356/bmj.i6583?ijkey=935824e1e99936eb88f0e5cdb5e9a0b60a405123&keytype2=tf_ipsecsha
Ponadto badanie wykazało korelację między poziomem witaminy D3 w organizmie a stopniem ciężkości zakażenia COVID-19 (oryginalny dokument do zamówienia):
4- Witamina C
„Niedobór witaminy C jest powszechny w zagrożonych populacjach (samotni mężczyźni, osoby starsze, bezdomne, zaburzenia psychiatryczne itp.) I jest niedoceniany w populacji ogólnej”.
Badania sugerują korzystną rolę podawania witaminy C w zapaleniu płuc wywołanym przez COVID19:
- https://clinicaltrials.gov/ct2/show/NCT04264533
- https://www.europereloaded.com/news-media-attacks-vitamin-c-treatment-of-covid-19-coronavirus-video/
- https://www.pressenza.com/fr/2020/04/de-la-vitamine-c-hautement-dosee-pour-prevenir-et-traiter-le-covid-19/
Jak widać, nie jest to pogląd umysłu ani nonsens, do którego dążą niektórzy ikonoklasty, daleki od tego. Zostało to również uwzględnione w niektórych protokołach amerykańskich:
- https://www.evms.edu/covid-19/covid_care_for_clinician/
- https://www.evms.edu/directory/profiles/paul-e-marik.php
– Dr Marik jest obecnie profesorem medycyny i dyrektorem medycyny pulmonologicznej i intensywnej terapii w Eastern Virginia Medical School w Norfolk w Wirginii. Dr Marik napisał ponad 400 recenzowanych artykułów w czasopismach, 50 rozdziałów w książkach i jest autorem czterech książek o intensywnej terapii.
Jak widać, hydroksychlorochina + azytromycyna jak najwcześniej (pierwszy dzień wystąpienia objawów), cynk, witaminy C i D mają należne im miejsce w leczeniu zakażeń wirusowych COVID-19!
Miejsce hydroksychlorochiny i azytromycyny:
- Faza wczesna (pierwszy dzień wystąpienia objawów)
- Leczenie przed-szpitalne (pacjenci dochodzący, lekarze pierwszego kontaktu)
Kontrola przez lekarzy pierwszego kontaktu, ambulatoryjnych lekarzy ogólnych lub lekarzy medycyny ratunkowej.
Miejsce cynku, witamin D i C:
- Leczenie przed-szpitalne
- Leczenie szpitalne
- Intensywna terapia
Zacznij od pomiaru poziomu tych 3 elementów we krwi. Następnie podaj zgodnie z istniejącymi protokołami. Niestety, obecnie, na większości oddziałów intensywnej terapii, (przynajmniej na Zachodzie), leczenie oprócz kortykosteroidów, (o którym od dawna wiadomo, że ma korzystny wpływ na ostrą naciekową chorobę śródmiąższową płuc), ogranicza się do leczenia objawowego i zapobiegania zakrzepicy :
- Terapia tlenowa
- Wentylacja nadciśnieniowa
- Pozycja na brzuchu
- Antykoagulacja w dawkach leczniczych.
- Kortykosteroidy (deksametazon, metyloprednizolon …)
Kiedy zostanie wdrożone monitorowanie poziomu cynku, witaminy C i D we krwi oraz agresywna korekta ich niedoborów?
Jest niedrogie, bezpieczne i okazało się skuteczne w infekcjach wirusowych, zwłaszcza dróg oddechowych. https://www.who.int/elena/titles/bbc/vitamind_pneumonia_children/fr/
– Niedobór witaminy D jest silnie powiązany z ryzykiem wystąpienia ostrych infekcji dolnych dróg oddechowych w wielu sytuacjach, według WHO!
COVID-19 w intensywnej terapii: Uwagi końcowe
Ostatnie słowo o obecnej sytuacji: wrzesień-październik 2020 r.
- Pierwsze przyjęcie na intensywną terapię 22 marca, ze szczytem w kwietniu (do 22 kwietnia) z 22 pacjentami z COVID-19 (na 39 łóżek). Silny spadek od maja (22 maja) z okresami bez pacjentów z COVID.
- Ostatni pacjent przyjęty na początku września 2020 roku, pomimo obecności poważnych czynników ryzyka (wiek, nadwaga, nadciśnienie), przebył łagodniejszą postać COvida-19 bez intubacji i w 8 dni hospitalizacji.
- Cięższe przypadki pojawiły się ponownie od 26 września, w bardzo małej liczbie. Nie było zgonów spowodowanych przez COVID-19 od 21 sierpnia 2020 r. Chociaż to wciąż zbyt wiele, tylko 8 zgonów od 2 czerwca 2020 r.
Odpowiada to oficjalnemu wykresowi przygotowanemu przez nasz organ ds. Zdrowia (Sciensano) w jego cotygodniowych biuletynach epidemiologicznych:
Wnioski
Choroba COVID-19 wywołana infekcją wirusową (SARS-CoV-2 z rodziny koronawirusów) w jej ciężkiej postaci, wymagająca hospitalizacji lub nawet przyjęcia na intensywną terapię, to rozlana naciekowa pneumopatia śródmiąższowa (PID), której głównym objawem jest zespół ostrej niewydolności oddechowej ARDS. ARDS jest znany od 1967 r. (pierwszy opis), stanowi około 10% przyjęć na intensywną terapię i charakteryzuje się wysoką śmiertelnością około 40-50%. Podobnie jak wszystkie PID, ta choroba płuc dobrze reaguje na kortykosteroidy, w możliwie dużych dawkach, co jest znane od lat.
Bezpośrednie zagrożenie życia wiąże się z ciężką hipoksemią, która może wymagać intensywnej tlenoterapii (wdychane powietrze wzbogacone do 100% O2), intubacji i sztucznej wentylacji pod dodatnim ciśnieniem, ułożenia na brzuchu i głębokiej sedacji (pacjent śpiący).
Osobliwością ARDS w przyapadku COVID jest to, że prowadzi do dużej skłonności do zakrzepicy naczyniowej (niedrożności naczyń krwionośnych). Na poziomie żylnym prowadzi to do dużego ryzyka zatorowości płucnej (nasilającej się hipoksemii), a na poziomie tętniczym – do dużego ryzyka zawału organicznego, szczególnie nerkowego lub mózgu (udar). Konieczna jest antykoagulacja w dawkach leczniczych. Może to być spowodowane obecnością przeciwciał autoimmunologicznych.
W Belgii, podobnie jak w innych krajach podlegających zarządzeniom WHO, zarządzania dotyczące COVID doprowadziły do wstrzymania innych działań zdrowotnych, zarówno medycznych, jak i chirurgicznych.
Z terapeutycznego punktu widzenia obiecujące, a nawet sprawdzone przydatne sposoby postępowania z COVID-19 zostały zignorowane:
We wczesnym stadium przedszpitalnym, od pierwszego dnia wystąpienia objawów:
- Hydroksychlorochina (HCQ) 400 mg / dobę przez 5 dni
- Azytromycyna, antybiotyk makrolidowy, w połączeniu z HCQ: synergia
- Cynk: w połączeniu z HCQ i Azytromycyną
Na etapie przedszpitalnym, szpitalnym i intensywnej terapii:
- Cynk
- Witamina D3
- Witamina C, możliwie w dużych dawkach we wlewie dożylnym (resuscytacja)
Artykuł w Journal of Infectious Diseases opublikowany w maju 2020 roku pokazuje, że użycie promieniowania ultrafioletowego (takiego jak promieniowanie słoneczne) przez sztuczne źródło światła szybko dezaktywuje SARS-CoV-2 na powierzchniach. https://academic.oup.com/jid/article/222/2/214/5841129
– Niniejsze badanie dostarcza pierwszych dowodów na to, że światło słoneczne może szybko dezaktywować SARS-CoV-2 na powierzchniach, co sugeruje, że trwałość, a następnie ryzyko narażenia mogą się znacznie różnić w zależności od środowiska wewnętrznego i zewnętrznego. Ponadto dane te wskazują, że naturalne światło słoneczne może skutecznie dezynfekować zanieczyszczone materiały nieporowate.
To badanie pokazuje, że światło słoneczne może szybko dezaktywować SARS-CoV-2 na powierzchniach… a dane te wskazują, że naturalne światło słoneczne może być również skuteczne jako środek dezynfekujący…
Czy nie mogłoby to korzystnie zastąpić chemicznych i toksycznych roztworów, które do tej pory były wyłączną domeną oficjalnych środków? Wydaje się, że nie ma drugiej fali lub licznych przypadków na skalę pierwszej fali z marca-kwietnia 2020 r. pod względem liczby przypadków i / lub ciężkości. – [Nie wiem, czy ten fragment jest obecnie aktualny (listopad 2020), w świetle sytuacji, która wygląda albo na stosowanie fałszywych statystyk albo na stymulowanie „pandemii” wirusem wyprodukowanym w laboratorium. – przyp. tłum.]
W świetle tego artykułu, wraz ze wszystkimi jego źródłami i odniesieniami naukowymi, niestosowanie hydroksychlorochiny, azytromycyny, cynku, witamin D3 i C jest niezrozumiałe, a jeśli legalne władze upierają się w tym zaprzeczeniu, uzasadnia to wszelkie podejrzenia co do ich legalności.
Dr Pascal Sacré
October 2020
Źródła i odniesienia znajdują się na końcu oryginalnego artykułu, tutaj:
Autor: Dr Pascal Sacré jest lekarzem specjalizującym się w opiece krytycznej (intensywnej terapii), autorem i znanym analitykiem zdrowia publicznego. Jest pracownikiem naukowym Centrum Badań nad Globalizacją
Artykuły d
- Covid-19 jako zespół ciężkiej niewydolności oddechowej (ARDS)
- Co to jest COVID-19? Siedem kluczowych punktów do zrozumienia SARS-CoV-2 i przeprowadzanych testów
- COVID-19 / RT-PCR, czyli jak zniszczyć ludzkość